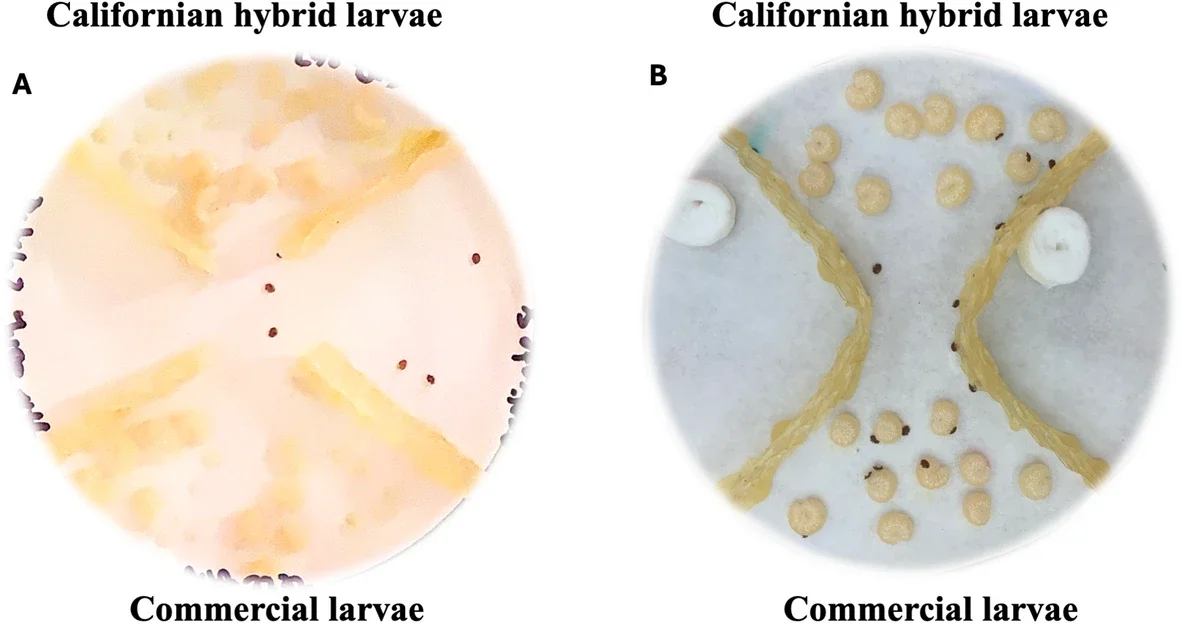
Experimental setup for Varroa mite host-choice assays using honey bee larvae of different ages and genotypes. (A) Choice arena testing for mite attractiveness to larvae of different ages (five to eight days). (B) Two-choice assay testing mite preference between genotypes.

In Southern California, some honeybees appear to be doing what many others across the country cannot: living with one of beekeeping’s most destructive parasites and keeping it under control.
That matters at a time when U.S. beekeepers are reporting severe losses. Managed honeybee colonies in the United States have faced annual losses of 40% to 50% in recent years, and losses reached as high as 62% in 2025, according to the source material behind a new study from the University of California, Riverside.
One of the biggest reasons is a parasite called Varroa destructor.
The mite reproduces inside brood cells and then feeds on adult bees, damaging tissue that bees need for basic survival. The study notes that mites remove fat body tissue, causing an 11% to 19% drop in body weight. They also help spread dangerous viruses, including deformed wing virus, acute bee paralysis virus, and black queen cell virus. Inside a colony, the damage builds. Bees struggle with learning and navigation, foraging suffers, and core tasks such as brood care and thermoregulation begin to break down.

Against that backdrop, researchers found that a locally adapted hybrid honeybee population in Southern California carried far lower mite burdens than commercial bees under the same management conditions.
“We kept hearing anecdotally that these Californian honeybees were surviving with way fewer treatments. I wanted to test them rigorously and understand the driving force behind what the beekeepers were seeing,” said Genesis Chong-Echavez, a UC Riverside graduate student and lead author of the study, published in Scientific Reports.
These bees are not a standard commercial stock. They come from a mixed population that has become widespread across Southern California, from San Diego to Fresno. Recent genetic analyses cited in the study describe them as hybrids with ancestry from Western European, Eastern European, Middle Eastern, and some African honeybees.
The study also notes that more than 60% of local beekeepers have begun keeping these bees for commercial or recreational purposes, according to a submitted survey by Chong-Echavez and colleagues.
To test whether the bees were actually more resistant to mites, researchers from UC Riverside’s Center for Integrative Bee Research monitored 236 colonies from 2019 to 2022. That produced 645 colony inspections in all, covering spring, summer, fall, and winter. Of those colonies, 135 were commercial and 101 were Californian hybrids.
The difference was hard to miss.

Commercial colonies averaged 4.83 mites per 100 adult bees. Californian hybrid colonies averaged 1.26. That is a 68.3% lower mite intensity in the hybrid bees. Mites were still common in both groups, appearing in 93.8% of inspections of commercial colonies and 85.3% of inspections of Californian hybrid colonies. But the local bees stayed well below the commercial group in both intensity and prevalence.
They also crossed the treatment threshold far less often. Commercial colonies exceeded the recommended threshold in 77.5% of inspections. Californian hybrid colonies did so in 53.5%. The odds of crossing that threshold were more than five times higher in commercial colonies, with an odds ratio of 5.2.
Boris Baer, a UC Riverside entomology professor and co-author of the study, said the project grew out of conversations with people already working in the field.
“This question did not start in the lab. It started in conversations with beekeepers,” Baer said. “They were not just observers; they helped shape the questions behind this research.”
The field data suggested the Californian bees were better at holding mite numbers down. The lab work pointed to a possible reason, and it showed up early in life.
Varroa mites must enter brood cells to reproduce, so the team tested whether mites were equally attracted to developing larvae from both bee types. In one set of host-choice experiments, the researchers ran 36 trials using 2,560 observations from larvae that were five, six, seven, and eight days old. The larvae came from 12 colonies, six from each genotype.
Across both groups, mites were most attracted to seven-day-old larvae. That timing matched earlier work showing that mites prefer late-stage larvae shortly before cell capping. Still, the two bee groups did not look the same.
Commercial larvae consistently attracted more mites than Californian hybrid larvae, though the size of the gap changed with larval age.
In a follow-up experiment focused only on seven-day-old larvae, the pattern held. The researchers ran nine behavioral trials using larvae from six colonies, three per genotype. Across that experiment, Californian hybrid larvae carried significantly fewer mites and had a lower probability of mite presence than commercial larvae.
The study reports that mites were detected on commercial larvae in nearly all trials, while Californian hybrid larvae were much less attractive. Mean mite attractiveness for Californian hybrid larvae was 0.64 ± 0.07, and mite presence averaged 58.3% ± 5.9%, compared with near-complete presence in commercial larvae.
That result stood out to Chong-Echavez.
“What surprised me most was the differences showed up even at the larval stage,” she said. “This suggests the resistance mechanism may go deeper than some kind of behavior and may be genetically built into the bees themselves.”
Adult worker behavior was excluded from these lab assays, which is why the researchers say the difference points to brood-level traits, not just colony behavior.

The study does not claim these bees are mite-free. It does not suggest abandoning current management practices either.
That caution matters because all colonies in the field study were managed under the same treatment rules. Colonies were treated when mite levels crossed intervention thresholds. As a result, the researchers say their findings reflect resistance-associated traits under managed conditions. They cannot yet say how untreated Californian hybrid colonies would compare over time. The study also notes that genotype categories were based on queen origin and local mating context, not full genomic assignment, which means variation within each group likely remains.
The authors point to other limitations as well. The powdered sugar shake used to measure mites has finite sensitivity, so lower prevalence in Californian hybrid colonies may partly reflect counts falling below detection levels. Laboratory choice assays also simplify real colony life. Mites will still invade brood even when hosts are not ideal, so the results indicate relative differences in attractiveness, not strict refusal.
Even so, the pattern was consistent.
Southern California may be an especially strong place for this kind of selection to happen. The study says the region’s mild winters and year-round brood production create ideal conditions for continuous mite reproduction. Unlike colder regions, where brood production pauses and mite numbers rise and fall with the seasons, Southern California colonies face persistent pressure. The researchers found no meaningful seasonal pattern in mite intensity or prevalence in either group. In that setting, any trait that reduces mite success could matter a great deal.
The team now wants to examine the genetic, behavioral, and chemical signals that may make Californian hybrid larvae less attractive. The paper points to possible differences in volatile emissions or cuticular hydrocarbons, both of which have been tied to mite attraction in earlier studies. It also raises the possibility that larval immune responses may play a role.
“At a time when pollinators are facing global decline, this work offers a hopeful message: solutions may already be emerging in the field, and we just need to understand them,” Chong-Echavez said.
This study suggests that part of beekeeping’s mite problem may be eased not only with chemicals, but with traits already present in certain honeybee populations.
If researchers can identify the genetic or chemical signals behind lower mite attraction, those traits could support breeding programs that reduce treatment needs and help colonies stay healthier under heavy parasite pressure.
For growers and beekeepers, that could eventually mean stronger pollination systems with less dependence on repeated mite suppression.
Research findings are available online in the journal Scientific Reports.
The original story “Southern California bees are keeping deadly mites in check” is published in The Brighter Side of News.
Like these kind of feel good stories? Get The Brighter Side of News’ newsletter.
The post Southern California bees are keeping deadly mites in check appeared first on The Brighter Side of News.
Leave a comment
You must be logged in to post a comment.